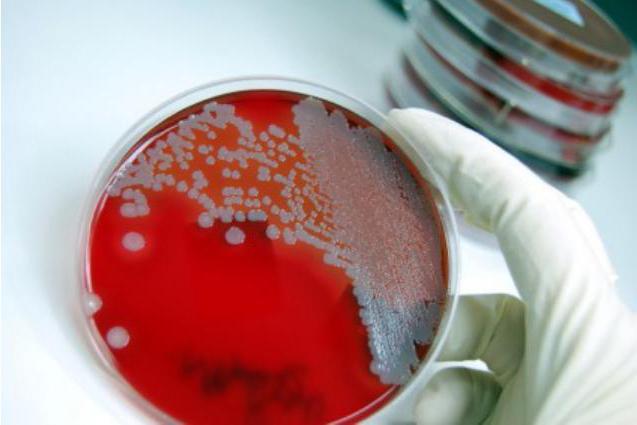
certificat épidémiologique

Ce formulaire est un document médical confirmant qu’un adulte ou sa progéniture n’avait aucun lien avec une personne atteinte d’une pathologie virale pendant une période allant jusqu’à 21 jours. Dans un environnement épidémiologique pur, il existe un vaste complexe de conditions externes. Ceux-ci comprennent:
- état de santé des proches (contacts quotidiens);
- manque de communication avec les patients sur le lieu de travail ou dans un établissement d'enseignement;
- situation positive dans la région.
Une personne peut dire qu’elle ou son enfant n’est pas infecté par une maladie infectieuse, mais les mots ne suffisent pas. Les autorités doivent fournir un document juridique rédigé par les épidémiologistes conformément à toutes les normes. C'est lorsque le citoyen lui-même et son entourage ont confiance dans la sécurité d'être à proximité que les incompréhensions et les peurs ne surviendront pas.
A quoi ressemble le document
Il contient trois sceaux, la signature de l'épidémiologiste, des informations sur qui et quand. Le formulaire doit indiquer que le citoyen n'a pas été exposé à l'infection pendant 21 jours. La ligne «Aide fournie» indique l’institution ou le lieu de travail requis. Le formulaire rempli indique l'état de santé complet de la personne qui a été examinée.

Il faut se rappeler que le certificat de contact a une date d'expiration de trois jours à compter de la date d'enregistrement. Par conséquent, il est rationnel de faire une telle chose pendant cette période au cours de laquelle vous devez soumettre un document pour examen par une institution spécialisée. Si un citoyen n'apporte pas le formulaire dans ce délai, le document est automatiquement considéré comme invalide, comme c'est le cas avec la carte spa. Si vous souhaitez savoir à quoi ressemble l'aide sur l'environnement épidémiologique, vous en trouverez un exemple dans l'article ci-dessus.
Pourquoi faire sortir?
Les autorités sanitaires de la Fédération de Russie doivent contrôler strictement le respect de la situation sanitaire et épidémiologique. C'est la tâche principale et la plus importante. La législation sanitaire énonce des mesures spécifiques qui devraient aider à prévenir la propagation des maladies infectieuses et diverses épidémies. Le système de santé est obligé de fonctionner correctement, en veillant principalement à protéger la population.
Toutes les mesures, qui incluent par exemple des procédures sanitaires et hygiéniques constantes, sont mises en œuvre pour le bien-être des citoyens. L’aide concernant l’environnement épidémiologique est un document important lié à ce système. Il peut être nécessaire dans certains centres médicaux, au travail et à l'école. Ces informations sont d'une grande importance dans la lutte contre l'épidémie de rougeole, de scarlatine, de varicelle et aident les organisations médicales des États à prévenir l'apparition de foyers de maladie dangereux.
Qui est recommandé de faire un document
Une référence sur l'environnement épidémiologique est nécessaire chaque fois qu'une personne change son environnement personnel pour un nouveau. Par exemple, s’il va dans une pension en vacances, dans un camp pour enfants ou dans un sanatorium sur le lac. De plus, sa présence est obligatoire lorsqu'un adulte retourne au travail et que l'enfant va à l'école, à la maternelle après de longues vacances ou une longue maladie.
Il y a toujours un risque d'infection si une personne visite activement des lieux surpeuplés. L'individu ne comprend pas toujours l'état de son immunité après de tels événements. C'est pourquoi ce document médical sauve les nerfs du propriétaire, en particulier des parents.
Comment obtenir de l'aide?
Un grand nombre de personnes s'intéressent à la question de savoir où obtenir de l'aide sur l'environnement épidémiologique. Vous devez comprendre que légalement, ce certificat ne peut être établi que par le biais du système SES (station sanitaire épidémiologique) de votre région.Les coordonnées de l'institution souhaitée sont faciles à trouver sur Internet.
Beaucoup de gens sont effrayés ou inquiets par l’idée d’une réception longue et difficile de ce document sérieux. Dans ce cas, il faut dépenser beaucoup d’énergie, faire la queue et faire face à l’incompétence du personnel. À ses risques et périls, un citoyen peut s'adresser à des entreprises clandestines en leur demandant de "tirer" un certificat dans un délai bref. Toutefois, il convient de rappeler que de telles actions sont illégales et peuvent entraîner des conséquences dangereuses pour vous et pour les personnes à proximité.
Certificat épidémiologique pour l'enfant. Où l'obtenir?
Dans l’environnement professionnel des médecins responsables de la délivrance du document, la position de ce certificat est double. Dans le meilleur des cas, si aucun foyer d’infection n’était enregistré dans la région, un certificat pour l’enfant serait délivré dans les meilleurs délais. Lorsque vous devez présenter un tel document à un citoyen non-résident, vous devez rassembler et présenter certains documents: notes sur le passage du FLG, tests de réussite ou certificat de vaccination. Le document pour l’enfant est délivré au bureau du pédiatre de la clinique pour enfants à laquelle appartient votre bébé.
Bref résumé
Une référence à l'environnement épidémiologique est le document le plus important prouvant qu'un citoyen n'est pas un colporteur d'une maladie virale et qu'il n'a pas été en contact avec un tel patient depuis trois semaines.
Pour obtenir ce certificat, vous devez contacter le SES régional. Après la soumission de certains documents, il sera délivré. Si un citoyen ne veut pas perdre du temps dans les files d'attente, il existe des sociétés spécialisées qui peuvent rapidement remplir un formulaire pour une petite quantité. Cependant, cette méthode n'est pas légale.
Le certificat rempli est habilité à demander sur le lieu de travail, dans les écoles et les jardins d'enfants après un congé de longue durée ou un congé de maladie. Il faut comprendre qu'un certificat d'un environnement épidémiologique favorable est nécessaire pour la sécurité générale de la population du pays.